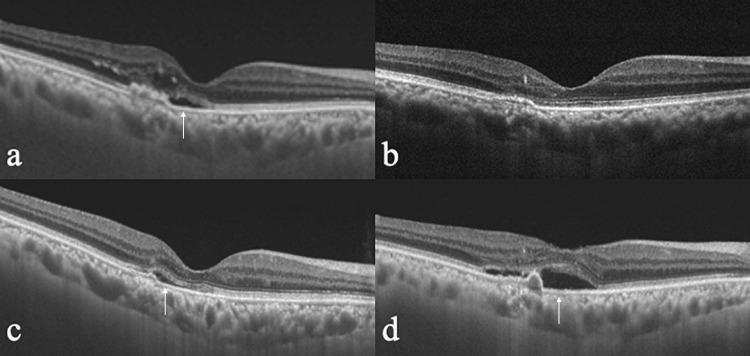
https://cdn.ncbi.nlm.nih.gov/pmc/blobs/1d1f/10797311/21e58a0cc3a7/cureus-0015-00000050817-i01.jpg

需要频繁注射抗血管内皮生长因子的新生血管性年龄相关性黄斑变性患者眼睛的特征
Characteristics of Eyes With Neovascular Age-Related Macular Degeneration Requiring Frequent Anti-vascular Endothelial Growth Factor Injections.
作者信息
Taketani Michiko, Arakawa Hisaya, Maruko Ichiro, Hasegawa Taiji, Iida Tomohiro
机构信息
Ophthalmology, Tokyo Women's Medical University, Tokyo, JPN.
出版信息
Cureus. 2023 Dec 20;15(12):e50817. doi: 10.7759/cureus.50817. eCollection 2023 Dec.
Objective In this study, we aimed to determine the characteristics of neovascular age-related macular degeneration (AMD) patients requiring frequent anti-vascular endothelial growth factor (VEGF) therapy. Methods This was a retrospective observational study involving the review of 32 eyes of 31 patients (25 men and six women, mean age: 74.3 years) treated with anti-VEGF injections for less than eight weeks and at least one year of follow-up. The subtype of macular neovascularization (MNV), follow-up duration, number of injections, visual acuity, and exudative changes during the study period were evaluated. Results Twenty-nine eyes (90.6%) had MNV under the retinal pigment epithelium (RPE), including 11 eyes with type 1 MNV and 18 eyes with polypoidal choroidal vasculopathy (PCV). Only three eyes had type 2 MNV (9.4%) above the RPE. The mean follow-up period was 28.7 ± 16.5 months, and the mean number of injections was 21.5 ± 11.8. The mean visual acuity [logarithm of the minimum angle of resolution (logMAR) units] was 0.19 ± 0.23 at the initial visit to our hospital, which decreased non-significantly to 0.24 ± 0.4 at the final visit (p=0.63). The exudation in four eyes (two with type 1 MNV and two with PCV) never resolved. The exudation remained in 27 eyes (84%) even after every four weeks of treatment, and it was present in five eyes (16%) in the treatment interval of eight weeks. Conclusions In the eyes receiving frequent anti-VEGF injections, the sub-RPE MNV might have affected the response to the treatment. Although patients requiring frequent anti-VEGF therapy did not have a significant decrease in their visual acuity, 84% of the eyes had exudations even with monthly injections.
目的 在本研究中,我们旨在确定需要频繁抗血管内皮生长因子(VEGF)治疗的新生血管性年龄相关性黄斑变性(AMD)患者的特征。方法 这是一项回顾性观察研究,涉及对31例患者(25例男性和6例女性,平均年龄:74.3岁)的32只眼睛进行回顾,这些患者接受抗VEGF注射治疗少于8周且随访至少1年。评估黄斑新生血管(MNV)的亚型、随访时间、注射次数、视力以及研究期间的渗出变化。结果 29只眼睛(90.6%)在视网膜色素上皮(RPE)下出现MNV,其中11只眼睛为1型MNV,18只眼睛为息肉样脉络膜血管病变(PCV)。只有3只眼睛(9.4%)在RPE上方出现2型MNV。平均随访期为28.7±16.5个月,平均注射次数为21.5±11.8次。在我院初诊时平均视力[最小分辨角对数(logMAR)单位]为0.19±0.23,在末次就诊时非显著性下降至0.24±0.4(p=0.63)。4只眼睛(2只1型MNV和2只PCV)的渗出从未消退。即使每4周治疗一次,27只眼睛(84%)仍有渗出,在8周的治疗间隔中有5只眼睛(16%)有渗出。结论 在接受频繁抗VEGF注射的眼睛中,RPE下的MNV可能影响了治疗反应。尽管需要频繁抗VEGF治疗的患者视力没有显著下降,但即使每月注射,84%的眼睛仍有渗出。